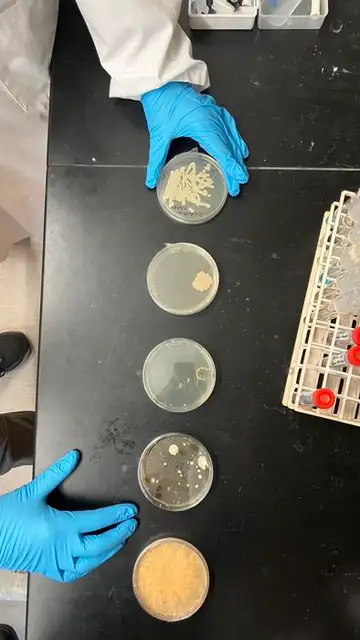
Placas de Petri que contienen colonias de los hongos patógenos Ustilago maydis y Cryptococcus neoformans, colonias de hongos aleatorias de muestras de aire y el hongo naranja Neurospora crassa Placas de Petri que contienen colonias de los hongos patógenos Ustilago maydis y Cryptococcus neoformans, colonias de hongos aleatorias de muestras de aire y el hongo naranja Neurospora crassa

HONGOS
La nueva temporada de The Last of Us acierta con la ciencia de acuerdo con este estudio
"Los patógenos fúngicos representan una amenaza importante que a menudo se pasa por alto", señalan los expertos del Imperial College de Londres.

Publicidad
Durante los últimos mil millones de años, el reino fúngico se ha diversificado hasta alcanzar más de dos millones de especies, de las cuales más del 95% aún no se han descrito. En pocas palabras: sabemos más de las profundidades marinas y del espacio, que de los hongos en el planeta que habitamos. Y, reduccionistas como somos los humanos, los dividimos (aquellos que conocemos) en dos categorías: buenos y malos… para nosotros.
Con los "buenos" hacemos levadura para panes, quesos, cervezas y hasta productos farmacéuticos. Los malos (para nosotros) son los que provocan infecciones fúngicas y representan riesgos para los ecosistemas, desde los cultivos hasta la fauna silvestre y los seres humanos. Pero uno de ellos es el protagonista de un éxito de ficción global, The Last of Us, la serie que estrena nueva temporada la semana que viene.
De acuerdo con el Matthew Fisher, del Imperial College de Londres, esta serie "es una fantástica exploración de las consecuencias distópicas de un brote de hongos. Si bien el escenario es improbable, tiene fundamentos biológicos. Hay cientos de especies de Cordyceps que han desarrollado a lo largo de milenios una asombrosa variedad de estrategias patógenas, algunas de ellas muy horripilantes".
Por ejemplo, existen "hongos zombi" que controlan a las hormigas, modificando el comportamiento de su huésped antes de salir de sus cabezas. Incluso existen paralelismos con otros parásitos no fúngicos, como el Toxoplasma gondii, que puede modificar el comportamiento de los roedores, y algunos han sugerido incluso la presencia de los humanos.
"Al igual que las bacterias o los virus, los hongos son antiguos y están en todas partes – añade Fisher -. De hecho, se cree que uno de los organismos más grandes de la Tierra es un hongo: una extensa red micorrízica que se encuentra en Estados Unidos. Al igual que las bacterias y los virus, algunos hongos tienen el potencial de causarnos daño, y los patógenos fúngicos representan una gran amenaza que a menudo se pasa por alto. Todos estamos expuestos a hongos potencialmente letales todos los días".
Claro que estamos caminando con un pie sobre la biología y otro en la distopía de la serie. La pregunta es: ¿se cruzan estos senderos? La respuesta podría ser afirmativa, de acuerdo con un reciente estudio publicado en Nature que señala que estamos ante la temporada más realista hasta la fecha.
El vídeo de publicidad de la serie de HBO parece mostrar al "hongo zombi" cordyceps (del cual existen unas 500 especies) infectando a humanos al liberar esporas en el aire, en lugar de a través de tentáculos, algo más cercano a la realidad científica.
"A los hongos les encanta producir esporas – explica Jim Kronstad, microbiólogo de la Universidad de British Columbia y líder del estudio -. El cordyceps real coloniza el cerebro de las hormigas, lo que hace que el insecto trepe a una rama alta. El hongo luego atraviesa la cabeza de la hormiga y esparce esporas sobre el suelo del bosque".
De hecho, muchas enfermedades fúngicas que infectan a los humanos, como Cryptococcus neoformans, que causa meningitis, se propagan por inhalación de esporas, añade el estudio.
Pero no es lo único en lo que la serie se anota un punto. En The Last of Us, el cordyceps, inofensivo e incluso comestible en la vida real, evolucionó a un hongo dañino debido al calentamiento global.
El equipo de Kronstad señalan al calentamiento global como un posible factor contribuyente a la propagación de hongos dañinos como el Coccidioides, causante de la fiebre del valle, y al aumento de Candida auris, que infecta a pacientes hospitalizados y es resistente a los antimicóticos disponibles.
A esto hay que sumarle el descubrimiento el año pasado de un nuevo hongo, el Rhodosporidiobolus fluvialis, en humanos, que anteriormente solo se había encontrado en el medio ambiente.
Pero la realidad (aclaramos, no la ficción), es muy distinta y los hongos son imprescindibles en la naturaleza. Reciclan materia orgánica muerta y actúan como enormes sumideros de carbono. Se pueden utilizar para fabricar materiales resistentes y ligeros, incluyendo materiales que podrían usarse en el espacio, como explica la NASA.
Hay otros "invasores" del cerebro mucho más peligrosos que los hongos. Y más reales.
Publicidad





